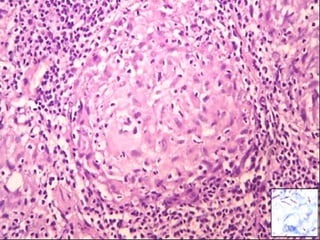
Cutaneous Tuberculosis
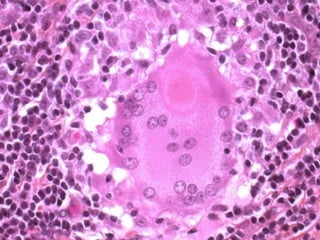
Cutaneous Tuberculosis
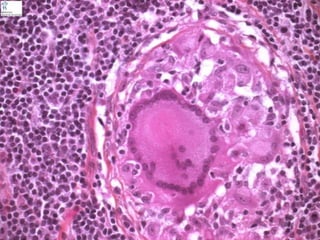
Cutaneous Tuberculosis

Embed presentation
Downloaded 63 times










































































































































The document discusses the latest advancements in renewable energy technologies. It highlights key innovations in solar, wind, and battery storage systems. Additionally, the document emphasizes the importance of governmental policies in promoting sustainable energy practices.